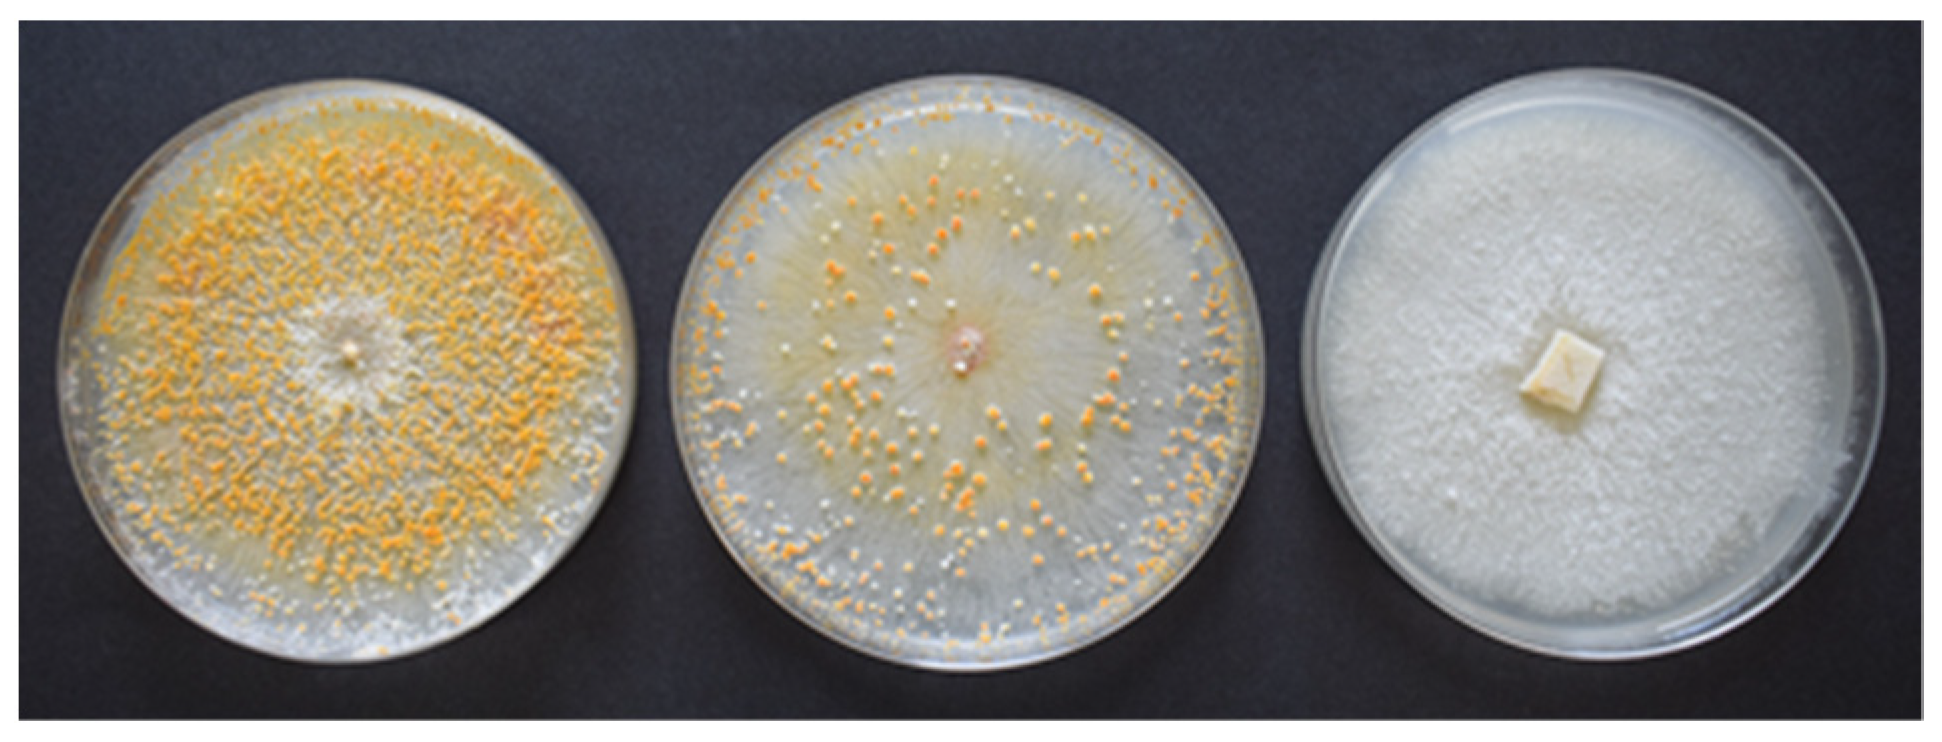
Agronomy 13 01208 g001 Agronomy 13 01208 g001

Various Population Structures of Cryphonectria parasitica in Cáceres (Spain) Determine the Feasibility of the Biological Control of Chestnut Blight with Hypovirulent Strains
Abstract
1. Introduction
2. Material and Methods
2.1. Survey, Sampling and Isolation of C. parasitica
2.2. Vegetative Compatibility Groups
2.3. Mating Types
2.4. Cryphonectria Hypovirus 1 (CHV-1) Detection, Sequencing and Phylogenetic Analysis
3. Results
3.1. Sampling and Isolation
3.2. Vegetative Compatibility Groups
3.3. Mating Type
3.4. Cryphonectria Hypovirus 1 (CHV-1) Detection and Subtype Determination
4. Discussion
5. Conclusions
Author Contributions
Funding
Informed Consent Statement
Data Availability Statement
Acknowledgments
Conflicts of Interest
References
- Anagnostakis, S.L. Chestnut blight: The classical problem of an introduced pathogen. Mycologia 1987, 79, 23–37. [Google Scholar] [CrossRef]
- Heiniger, U.; Rigling, D. Biological control of chestnut blight in Europe. Annu. Rev. Phytopathol. 1994, 32, 581–599. [Google Scholar] [CrossRef]
- Krstin, L.; Novak-Agbaba, S.; Rigling, D.; Krajačić, M.; Ćurković-Perica, M. Chestnut blight fungus in Croatia: Diversity of vegetative compatibility types, mating types and genetic variability of associated Cryphonectria hypovirus 1. Plant Pathol. 2008, 57, 1086–1096. [Google Scholar] [CrossRef]
- Prospero, S.; Rigling, D. Invasion genetics of the chestnut blight fungus Cryphonectria parasitica in Switzerland. Phytopathology 2012, 102, 73–82. [Google Scholar] [CrossRef]
- Rigling, D.; Prospero, S. Cryphonectria parasitica, the causal agent of chestnut blight: Invasion history, population biology and disease control. Mol. Plant Pathol. 2018, 19, 7–20. [Google Scholar] [CrossRef]
- Hunter, G.C.; Wylder, B.; Webber, J.F. First finding of Cryphonectria parasitica causing chestnut blight on Castanea sativa trees in England. New Dis. Rep. 2013, 27, 1. [Google Scholar] [CrossRef]
- Pérez-Sierra, A.; Romón-Ochoa, P.; Gorton, C.; Lewis, A.; Rees, H.; van der Linde, S.; Webber, J. High vegetative compatibility diversity of Cryphonectria parasitica infecting sweet chestnut (Castanea sativa) in Britain indicates multiple pathogen introductions. Plant Pathol. 2019, 68, 727–737. [Google Scholar] [CrossRef]
- Romón-Ochoa, P.; Orlovic, J.K.; Gorton, C.; Lewis, A.; van der Linde, S.; Pérez-Sierra, A. New detections of chestnut bligth in Great Britain during 2019-2020 reveal high Cryphonectria parasitica diversity and limited spread of the disease. Plant Pathol. 2021, 71, 793–804. [Google Scholar] [CrossRef]
- Marra, R.E.; Milgroom, M.G. The mating system of the fungus Cryphonectria parasitica: Selfing and self-incompatibility. Heredity 2001, 86, 134–143. [Google Scholar] [CrossRef]
- Bissegger, M.; Rigling, D.; Heiniger, U. Population structure and disease development of Cryphonectria parasitica in European chestnut forests in the presence of natural hypovirulence. Phytopathology 1997, 87, 50–59. [Google Scholar] [CrossRef] [PubMed]
- Marra, R.E.; Cortesi, P.; Bissegger, M.; Milgroom, M.G. Mixed mating in natural populations of the chestnut blight fungus, Cryphonectria parasitica. Heredity 2004, 93, 189–195. [Google Scholar] [CrossRef] [PubMed]
- Choi, G.H.; Nuss, D.L. Hypovirulence of chestnut blight fungus conferred by an infectious viral cDNA. Science 1992, 257, 800–803. [Google Scholar] [PubMed]
- Milgroom, M.G.; Cortesi, P. Biological control of chestnut blight with hypovirulence: A critical analysis. Annu. Rev. Phytopathol. 2004, 42, 311–338. [Google Scholar] [CrossRef] [PubMed]
- Cortesi, P.; Milgroom, M.G. Genetics of vegetative incompatibility in Cryphonectria Parasit. Appl. Environ. Microb. 1998, 64, 2988–2994. [Google Scholar] [CrossRef]
- Liu, Y.C.; Milgroom, M.G. Correlation between hypovirus transmission and the number of vegetative incompatibility (vic) genes different among isolates from a natural populations of Cryphonectria parasitica. Phytopathology 1996, 86, 1344–1451. [Google Scholar] [CrossRef]
- Cortesi, P.; McCulloch, C.E.; Song, H.Y.; Lin, H.Q.; Milgroom, M.G. Genetic control of horizontal virus transmission in the chestnut blight fungus, Cryphonectria Parasit. Genetics 2001, 159, 107–118. [Google Scholar] [CrossRef] [PubMed]
- Robin, C.; Anziani, C.; Cortesi, P. Relationship between biological control, incidence of hypovirulence, and diversity of vegetative compatibility types of Cryphonectria parasitica in France. Phytopathology 2000, 90, 730–737. [Google Scholar] [CrossRef]
- Anagnostakis, S.L.; Hau, B.; Kranz, J. Diversity of vegetative compatibility groups of Cryphonectria parasitica in Connecticut and Europe. Plant Dis. 1986, 70, 536–538. [Google Scholar] [CrossRef]
- MacDonald, W.L.; Fulbright, D.W. Biological control of chestnut blight use and limitations of transmissible hypovirulence. Plant Dis. 1991, 75, 656–661. [Google Scholar] [CrossRef]
- Prospero, S.; Conedera, M.; Heiniger, U.; Rigling, D. Saprophytic activity and sporulation of Cryphonectria parasitica on dead chestnut wood in forests with naturally established hypovirulence. Phytopathology 2006, 96, 1337–1344. [Google Scholar] [CrossRef]
- Heiniger, U.; Rigling, D. Application of the Cryphonectria Hypovirus (CHV-1) to control the chestnut blight, experience from Switzerland. Acta Hortic. 2009, 815, 233–245. [Google Scholar] [CrossRef]
- Robin, C.; Lanz, S.; Soutrenon, A.; Rigling, D. Dominance of natural over released biological control agents of the chestnut blight fungus Cryphonectria parasitica in southeastern France is associated with fitness-related traits. Biol. Control 2010, 53, 55–61. [Google Scholar] [CrossRef]
- Prospero, S.; Rigling, D. Using molecular markers to assess the establishment and spread of a mycovirus applied as a biological control agent against chestnut blight. Biocontrol 2016, 61, 313–323. [Google Scholar] [CrossRef]
- Diamandis, S. Management of chestnut blight in Greece using hypovirulence and silvicultural interventions. Forests 2018, 9, 492–498. [Google Scholar] [CrossRef]
- de Castilla y León, J. El Chancro Del Castaño: Cryphonectria parasit. 2023. Available online: https://medioambiente.jcyl.es/web/es/medio-natural/chancro-castano-cryphonectria-parasitica.html (accessed on 14 March 2023).
- Coelho, V.; Nunes, L.; Gouveia, E. Short and long term efficacy and prevalence of Cryphonectria parasitica hypovirulent strains released as biocontrol agents of chestnut blight. Eur. J. Plant Pathol. 2021, 159, 769–781. [Google Scholar] [CrossRef]
- Allemann, C.; Hoegger, P.; Heiniger, U.; Rigling, D. Genetic variation of Cryphonectria hypoviruses (CHV1) in Europe, assessed using restriction fragment length polymorphism (RFLP) markers. Mol. Ecol. 1999, 8, 843–854. [Google Scholar] [CrossRef] [PubMed]
- Gobbin, D.; Hoegger, P.J.; Heiniger, U.; Rigling, D. Sequence variation and evolution of Cryphonectria hypovirus 1 (CHV-1) in Europe. Virus Res. 2003, 97, 39–46. [Google Scholar] [CrossRef] [PubMed]
- Rigling, D.; Borst, N.; Cornejo, C.; Supatashvili, A.; Prospero, S. Genetic and phenotypic characterization of Cryphonectria hypovirus 1 from Eurasian Georgia. Viruses 2018, 10, 687. [Google Scholar] [CrossRef] [PubMed]
- MAPA. Avance de datos de Frutales no cítricos y Frutales secos 2021. In Crop Surface Areas and Annual Production from Ministry of Agriculture, Fisheries and Food (Government of Spain); MAPA: Palacio de Fomento Madrid, Spain, 2022; Available online: https://www.mapa.gob.es/es/estadistica/temas/estadisticas-agrarias/agricultura/superficies-producciones-anuales-cultivos/ (accessed on 22 March 2023).
- McGuire, I.C.; Marra, R.E.; Milgroom, M.G. Mating-type heterokaryosis and selfing in Cryphonectria parasitica. Fungal Genet. Biol. 2004, 41, 521–533. [Google Scholar] [CrossRef]
- Feau, N.; Dutech, C.; Brusini, J.; Rigling, D.; Robin, C. Multiple introductions and recombination in Cryphonectria hypovirus 1: Perspective of a sustainable biological control of chestnut blight. Evol. Appl. 2014, 9, 580–596. [Google Scholar] [CrossRef]
- Thompson, J.D.; Higgins, D.G.; Gibson, T.J. CLUSTAL W: Improving the sensitivity of progressive multiple sequence alignment through sequence weighting, position-specific gap penalties and weight matrix choice. Nucleic Acids Res. 1994, 22, 4673–4680. [Google Scholar] [CrossRef] [PubMed]
- Castaño, C.; Bassie, L.; Oliach, D.; Gomez, M.; Medina, V.; Liu, B.; Colinas, C. Cryphonectria hypovirus 1 (CHV-1) survey reveals low occurrence and diversity of subtypes in NE Spain. For. Pathol. 2015, 45, 51–59. [Google Scholar] [CrossRef]
- Tamura, K.; Stecher, G.; Kumar, S. MEGA11: Molecular Evolutionary Genetics Analysis version 11. Mol. Biol. Evol. 2021, 38, 3022–3027. [Google Scholar] [CrossRef]
- Felsenstein, J. Confidence limits on phylogenies—An approach using the bootstrap. Evolution 1985, 39, 783–791. [Google Scholar] [CrossRef]
- Cortesi, P.; Milgroom, M.G.; Bisiach, M. Distribution and diversity of vegetative compatibility types in subpopulations of Cryphonectria parasitica in Italy. Mycol. Res. 1996, 100, 1087–1093. [Google Scholar] [CrossRef]
- Bragança, H.; Simões, S.; Onofre, N.; Tenreiro, R.; Rigling, D. Cryphonectria parasitica in Portugal: Diversity of vegetative compatibility types, mating types, and occurrence of hypovirulence. For. Pathol. 2007, 37, 391–402. [Google Scholar] [CrossRef]
- Gouveia, E.; Pereira, E.; Araújo, A.; Coelho, V.; Castro, J.; Bragança, H.; Martins, L. Cancro do Castanheiro em Trás-os-Montes (Portugal): Incidência atual e estudo da estrutura populacional de Cryphonectria parasitica para a introdução da luta biológica por hipovirulência. Gaia Sci. 2016, 10, 75–83. [Google Scholar] [CrossRef]
- Zamora, P.; Martin, A.B.; Rigling, D.; Diez, J.J. Diversity of Cryphonectria parasitica in western Spain and identification of hypovirus-infected isolates. For. Pathol. 2012, 42, 412–419. [Google Scholar] [CrossRef]
- Milgroom, M.G.; Sotirovski, K.; Spica, D.; Davis, J.E.; Brewer, M.T.; Milev, M.; Cortesi, P. Clonal population structure of the chestnut blight fungus in expanding ranges in southeastern Europe. Mol. Ecol. 2008, 17, 4446–4458. [Google Scholar] [CrossRef]
- Perlerou, C.; Diamandis, S. Identification and geographic distribution of vegetative compatibility types of Cryphonectria parasitica and occurrence of hypovirulence in Greece. For. Pathol. 2006, 36, 413–421. [Google Scholar] [CrossRef]
- Sotirovski, K.; Milgroom, M.G.; Rigling, D.; Heiniger, U. Occurrence of Cryphonectria hypovirus 1 in the chestnut blight fungus in Macedonia. For. Pathol. 2006, 36, 136–143. [Google Scholar] [CrossRef]
- Ahmad, F.; Baric, S. Genetic diversity of Cryphonectria parasitica causing chestnut blight in South Tyrol (northern Italy). Eur. J. Plant Pathol. 2022, 162, 621–635. [Google Scholar] [CrossRef]
- Griffin, G.J. Chestnut blight and its control. Hortic. Rev. 1986, 8, 291–336. [Google Scholar]
- Montenegro, D.; Aguin, O.; Sainz, M.J.; Hermida, M.; Mansilla, J.P. Diversity of vegetative compatibility types, distribution of mating types and occurrence of hypovirulence of Cryphonectria parasitica in chestnut stands in NW Spain. For. Ecol. Manag. 2008, 256, 973–980. [Google Scholar] [CrossRef]
- González-Varela, G.; González, A.J.; Milgroom, M.G. Clonal population structure and introductions of the chestnut blight fungus, Cryphonectria parasitica, in Asturias, northern Spain. Eur. J. Plant Pathol. 2011, 131, 67–79. [Google Scholar] [CrossRef]
- Robin, C.; Heiniger, U. Chestnut blight in Europe: Diversity of Cryphonectria parasitica, hypovirulence and biocontrol. For. Snow Landsc. Res. 2001, 76, 361–367. [Google Scholar]
- Trapiello, E.; Rigling, D.; González, A.J. Occurrence of hypovirus-infected Cryphonectria parasitica isolates in northern Spain: An encouraging situation for biological control of chestnut blight in Asturian forests. Eur. J. Plant Pathol. 2017, 149, 503–514. [Google Scholar] [CrossRef]
- Risteski, M.; Milev, M.; Rigling, D.; Milgroom, M.G.; Bryner, S.F.; Sotirovski, K. Distribution of chestnut blight and diversity of Cryphonectria parasitica in chestnut forests in Bulgaria. For. Pathol. 2013, 43, 437–443. [Google Scholar] [CrossRef]
- Adamcikova, K.; Ondruskova, E.; Kadasi-Horakova, M.; Botu, M.; Kobza, M.; Achim, G. Distribution and population structure of the chestnut blight fungus in Romania. Plant Protect. Sci. 2015, 51, 141–149. [Google Scholar] [CrossRef]
- Chen, B.; Nuss, D.L. Infectious cDNA clone of hypovirus CHV1-Euro7: A comparative virology approach to investigate virus-mediated hypovirulence of chestnut blight fungus Cryphonectria parasitica. J. Virol. 1999, 73, 985–992. [Google Scholar] [CrossRef] [PubMed]
- Krstin, L.; Novak-Agbaba, S.; Rigling, D.; Ćurković Perica, M. Diversity of vegetative compatibility types and mating types of Cryphonectria parasitica in Slovenia and occurrence of associated Cryphonectria hypovirus 1. Plant Pathol. 2011, 60, 752–761. [Google Scholar] [CrossRef]
- Akilli, S.; Serce, C.U.; Katircioglu, Y.Z.; Maden, S.; Rigling, D. Characterization of hypovirulent isolates of the chestnut blight fungus, Cryphonectria parasitica from the Marmara and Black Sea regions of Turkey. Eur. J. Plant Pathol. 2013, 135, 323–334. [Google Scholar] [CrossRef]
- Peters, F.S.; Busskamp, J.; Prospero, S.; Rigling, D.; Metzler, B. Genetic diversification of the chestnut blight fungus Cryphonectria parasitica and its associated hypovirus in Germany. Fungal Biol. 2014, 118, 193–210. [Google Scholar] [CrossRef] [PubMed]

Disclaimer/Publisher’s Note: The statements, opinions and data contained in all publications are solely those of the individual author(s) and contributor(s) and not of MDPI and/or the editor(s). MDPI and/or the editor(s) disclaim responsibility for any injury to people or property resulting from any ideas, methods, instructions or products referred to in the content. |
© 2023 by the authors. Licensee MDPI, Basel, Switzerland. This article is an open access article distributed under the terms and conditions of the Creative Commons Attribution (CC BY) license (https://creativecommons.org/licenses/by/4.0/).
Share and Cite
Rodríguez-Molina, M.d.C.; García-García, M.B.; Osuna, M.D.; Gouveia, E.; Serrano-Pérez, P. Various Population Structures of Cryphonectria parasitica in Cáceres (Spain) Determine the Feasibility of the Biological Control of Chestnut Blight with Hypovirulent Strains. Agronomy 2023, 13, 1208. https://doi.org/10.3390/agronomy13051208
Rodríguez-Molina MdC, García-García MB, Osuna MD, Gouveia E, Serrano-Pérez P. Various Population Structures of Cryphonectria parasitica in Cáceres (Spain) Determine the Feasibility of the Biological Control of Chestnut Blight with Hypovirulent Strains. Agronomy. 2023; 13(5):1208. https://doi.org/10.3390/agronomy13051208
Chicago/Turabian StyleRodríguez-Molina, María del Carmen, María Blanca García-García, María Dolores Osuna, Eugénia Gouveia, and Paula Serrano-Pérez. 2023. "Various Population Structures of Cryphonectria parasitica in Cáceres (Spain) Determine the Feasibility of the Biological Control of Chestnut Blight with Hypovirulent Strains" Agronomy 13, no. 5: 1208. https://doi.org/10.3390/agronomy13051208
APA StyleRodríguez-Molina, M. d. C., García-García, M. B., Osuna, M. D., Gouveia, E., & Serrano-Pérez, P. (2023). Various Population Structures of Cryphonectria parasitica in Cáceres (Spain) Determine the Feasibility of the Biological Control of Chestnut Blight with Hypovirulent Strains. Agronomy, 13(5), 1208. https://doi.org/10.3390/agronomy13051208

